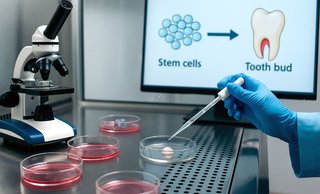

Что именно нашли
В экспериментах на генетически модифицированных мышах учёные «проследили родословную» клеток в зоне формирования корня. Нашлись две популяции: одни предшественники дают начало клеткам корня (одонтобластам/цементобластам) и при определённых условиях могут участвовать в построении кости; другие — из околозубного мешочка — формируют элементы пародонта (связки, кость). Проще: у зарождающегося зуба есть «резерв» клеток, которые умеют переключаться между задачами — строить корень и укрепляющую его кость.
Для пациента это означает, что будущие методы могут точнее адресоваться к нужной ткани: отдельно — к корню, отдельно — к кости и связкам, а не «одним мазком по всему пародонту».
Почему это важно для практики
Сегодня мы умеем надёжно заменять утраченные зубы (импланты, протезы), но не умеем полноценно восстанавливать собственный зуб с корнем и связкой. Корень и альвеолярная кость — это «связка», которая даёт естественные ощущения и биологическую интеграцию. Новые данные объясняют, какие сигналы (например, пути Wnt и Hedgehog) включают нужные сценарии созревания стволовых клеток — без этого невозможна точная регенерация.
Отсюда логика следующего шага: научиться «подталкивать» конкретные предшественники к нужной роли — наращивать корневые ткани либо кость вокруг зуба/импланта.
На каком этапе исследования сейчас
Важно понимать ограничение: результаты получены на животных моделях и в условиях лаборатории. До клиники нужно пройти путь безопасности, доз, способов доставки клеток/сигналов и доказательств того, что регенерат долговечен и функционален (жует, не воспаляется, проводит нагрузку).
Параллельно в мире уже стартуют первые клинические испытания лекарств, нацеленных на «перезапуск» зубообразования — но это другая линия исследований и другие механизмы. В любом случае речь о годах, а не неделях.
Что это значит для пациента уже сегодня
Менять план лечения из-за новости не нужно. Если зуб утрачен — стандартом остаётся имплантация/протезирование по показаниям; если десны воспалены — лечим пародонт и берём ремиссию под контроль. Регенерация — перспектива, а не замена базовой терапии.
- Есть воспаление десен или карманы? Начинаем с лечения десен и регулярной поддерживающей гигиены.
- Есть рецессии (оголение корней) или дефицит мягких тканей? Рассмотрите пластику десны и лечение рецессии.
- Подвижность зубов после воспаления? По показаниям помогает шинирование и разгрузка при бруксизме.
- Кариес и трещины? Сначала санация зубов, далее — контроль факторов риска (сон, стресс, сахар, курение).
Так вы сохраните максимум собственных тканей сегодня и создадите лучшие условия на будущее — когда регенеративные технологии доедут до клиники.
FAQ — короткие ответы
Можно ли уже «вырастить» зуб человеку?
Нет. Работы идут, но клинической, массово доступной технологии сейчас нет.
Заменит ли это импланты?
В обозримом горизонте — нет. Имплантация остаётся золотым стандартом при потере зуба. Регенерация — потенциальное дополнение в отдельных сценариях будущего.
Безопасно ли это?
Любая клеточная/сигнальная терапия проходит этапы проверки: от лаборатории к животным, затем к испытаниям у людей. До одобрения и рекомендаций — это наука, а не услуга.
Висновок
Открытие уточнило «карту» стволовых клеток зуба и кости и описало сигналы, которые ими управляют. Это серьёзная теоретическая база под будущую регенерацию корней и пародонта. На практике прямо сейчас выигрывает тот, кто вовремя лечит воспаление, бережно восстанавливает разрушения и ходит на профилактику. Если есть вопросы по вашей ситуации — запишитесь на очную диагностику: начните с лечения десен и плановой поддерживающей гигиены, а затем обсудите долгосрочную стратегию.